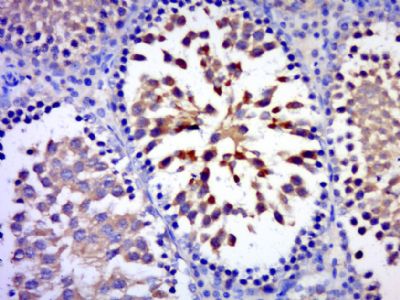
产品细节图片2

相关产品推荐更多 >
万千商家帮你免费找货
0 人在求购买到急需产品
- 详细信息
- 文献和实验
- 技术资料
- 供应商:
上海联迈生物工程有限公司
- 库存:
大量
- 目录编号:
LM-9646R
- 克隆性:
多克隆
- 抗原来源:
Rabbit
- 保质期:
1年
- 抗体英文名:
C17orf75
- 抗体名:
17号染色体开放阅读框75抗体
- 宿主:
Rabbit
- 适应物种:
Human, Mouse, Rat, Dog, Horse, Sheep,
- 免疫原:
KLH conjugated synthetic peptide derived from human C17orf75:201-300/396
- 亚型:
IgG
- 形态:
Lyophilized or Liquid
- 应用范围:
WB=1:500-2000 ELISA=1:500-1000 IHC-P=1:400-800 IHC-F=1:400-800 ICC=1:100-500 IF=1:100-500 (石蜡切片需做抗原修复)
- 浓度:
1mg/ml
- 保存条件:
Store at -20 °C
- 规格:
100ul 200ul
| 英文名称 | C17orf75 |
| 中文名称 | 17号染色体开放阅读框75抗体 |
| 别 名 | Njmu R1; Protein kinase Njmu R1; Protein Njmu R1; NJMU_HUMAN. |
| 规格价格 | 100ul/1380元 购买 200ul/2200元 购买 大包装/询价 |
| 说 明 书 | 100ul 200ul |
| 研究领域 | 肿瘤 细胞生物 免疫学 信号转导 |
| 抗体来源 | Rabbit |
| 克隆类型 | Polyclonal |
| 交叉反应 | Human, Mouse, Rat, Dog, Horse, Sheep, |
| 产品应用 | WB=1:500-2000 ELISA=1:500-1000 IHC-P=1:400-800 IHC-F=1:400-800 ICC=1:100-500 IF=1:100-500 (石蜡切片需做抗原修复) not yet tested in other applications. optimal dilutions/concentrations should be determined by the end user. |
| 分 子 量 | 45kDa |
| 细胞定位 | 细胞核 细胞浆 |
| 性 状 | Lyophilized or Liquid |
| 浓 度 | 1mg/ml |
| 免 疫 原 | KLH conjugated synthetic peptide derived from human C17orf75:201-300/396 |
| 亚 型 | IgG |
| 纯化方法 | affinity purified by Protein A |
| 储 存 液 | 0.01M TBS(pH7.4) with 1% BSA, 0.03% Proclin300 and 50% Glycerol. |
| 保存条件 | Store at -20 °C for one year. Avoid repeated freeze/thaw cycles. The lyophilized antibody is stable at room temperature for at least one month and for greater than a year when kept at -20°C. When reconstituted in sterile pH 7.4 0.01M PBS or diluent of antibody the antibody is stable for at least two weeks at 2-4 °C. |
| PubMed | PubMed |
| 产品介绍 | background: C17orf75 is a 396 amino acid protein that is encoded by a gene mapping to human chromosome 17. Chromosome 17 makes up over 2.5% of the human genome with about 81 million bases encoding over 1,200 genes. Two key tumor suppressor genes are associated with chromosome 17, namely, p53 and BRCA1. Tumor suppressor p53 is necessary for maintenance of cellular genetic integrity by moderating cell fate through DNA repair versus cell death. Malfunction or loss of p53 expression is associated with malignant cell growth and Li-Fraumeni syndrome. Like p53, BRCA1 is directly involved in DNA repair, specifically it is recognized as a genetic determinant of early onset breast cancer and predisposition to cancers of the ovary, colon, prostate gland and fallopian tubes. Chromosome 17 is also linked to neurofibromatosis, a condition characterized by neural and epidermal lesions, and dysregulated Schwann cell growth. Alexander disease, Birt-Hogg-Dube syndrome and Canavan disease are also associated with chromosome 17. Tissue Specificity: The molecular function and cellular component of this protein are unknown. It may have a role in spermatogenesis, is highly expressed in testis and is also expressed in fetal testis. SWISS: Q9HAS0 Gene ID: 64149 Database links: Entrez Gene: 64149 Human SwissProt: Q9HAS0 Human Unigene: 462754 Human Important Note: This product as supplied is intended for research use only, not for use in human, therapeutic or diagnostic applications. |
| 产品图片 | ![]() Sample: U2os Cell (Human) Lysate at 30 ug Primary: Anti- C17orf75 (bs-9646R)at 1/300 dilution Secondary: IRDye800CW Goat Anti-Rabbit IgG at 1/20000 dilution Predicted band size: 45kD Observed band size: 45kD ![]() Paraformaldehyde-fixed, paraffin embedded (rat testis); Antigen retrieval by boiling in sodium citrate buffer (pH6.0) for 15min; Block endogenous peroxidase by 3% hydrogen peroxide for 20 minutes; Blocking buffer (normal goat serum) at 37°C for 30min; Antibody incubation with (C17orf75) Polyclonal Antibody, Unconjugated (bs-9646R) at 1:400 overnight at 4°C, followed by a conjugated secondary (sp-0023) for 20 minutes and DAB staining. |
风险提示:丁香通仅作为第三方平台,为商家信息发布提供平台空间。用户咨询产品时请注意保护个人信息及财产安全,合理判断,谨慎选购商品,商家和用户对交易行为负责。对于医疗器械类产品,请先查证核实企业经营资质和医疗器械产品注册证情况。
文献和实验长度为1450bp即483个密码子,最长的是位于XII号染色体上的一个功能未知的开放阅读框(4910个密码子),还有极少数的开放阅读框长度超过1500个密码子。在酵母基因组中,也有编码短蛋白的基因,例如,编码由40个氨基酸组成的细胞质 膜蛋白 脂质的PMP1基因。此外,酵母基因组中还包含:约140个编码RNA的基因,排列在XII号染色体的长末端;40个编码SnRNA的基因,散布于16条染色体;属于43个家族的275个tRNA基因也广泛分布于基因组中。 表1 酵母染色体
,即整个基因组有72%的核苷酸顺序由开放阅读框组成。这说明酿酒酵母基因要比其它高等真核生物基因排列紧密。如在人类基因组中,大约平均每隔30kb或更多的碱基才能发现一个编码蛋白质的基因。酵母基因组的紧密性是因为基因间隔区较短与基因中内含子稀少。酵母基因组的开放阅读框平均长度为483个密码子,最长的是位于XII号染色体上的一个功能未知的开放阅读框(4910个密码子)。此外,酿酒酵母基因组中还包含有大约140个编码rRNA的基因,排列在XII号染色体的长末端;40个编码snRNA(small nuclear
腺相关病毒载体介导的基因转移 腺相关病毒(adeno―associated virus,AAV)是一种单链DNA病毒,属微小病毒科依赖性病毒属。通常情况下,AAV感染细胞后可以原病毒的形式整合到宿主细胞染色体上,随细胞染色体一起复制;当有辅助病毒(如腺病毒、单纯疱疹病毒等)存在时,AAV基因组可被拯救出来,即产生有感染活性的AAV。20世纪80年代,AAV全基因组的克隆为AAV分子生物学研究以及AAV载体构建奠定了基础。迄今腺病毒相关病毒已发现9个血清型,根据其抗体交叉
技术资料暂无技术资料 索取技术资料